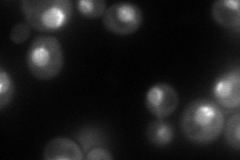
YCR086W
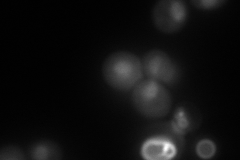
YCR086W

View description
Nucleolar protein that forms a complex with Lrs4p and then Mam1p at kinetochores during meiosis I to mediate accurate homolog segregation; required for condensin recruitment to the replication fork barrier site and rDNA repeat segregation
Localization:
Intensity:
Fold change:
Significance:
-
C’ GFP library in SD

below threshold19.54 -
N' NOP1pr-GFP in SD
punctate,nucleus110.599 -
N' TEF2pr-mCherry in SD
nucleus145.171 -
N' NATIVEpr-GFP in SD

punctate21.5025 -
N' TEF2pr-VC and Cyto-VN in SD

nucleus,nucleolus38.2678 -
C’ GFP library in SD+DTT

cytosol14.270.73No -
C’ GFP library in SD+H2O2

cytosol14.990.76No -
C’ GFP library in Starvation Media

cytosol15.140.77No -
C’ GFP library on the background of Pup2-DaMP

below threshold -
C’ GFP library on the background of CCT mutant

below threshold17.59650.900014No
